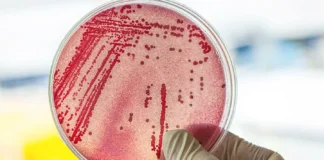
Cuatro playas de Minneapolis cierran debido a bacteria Cuatro playas de Minneapolis cierran debido a bacteria

La demolición del Kmart en Lake Street en Minneapolis comenzó el martes por la mañana. Si bien los funcionarios no han dicho exactamente qué le depara el futuro al lote, está previsto que los equipos de demolición estén en el lugar toda la semana trabajando en el edificio, según un funcionario de la ciudad.
Según la nota de Canal 5 ABC, la tienda cerró en 2020 y ha estado prácticamente vacía desde entonces, a excepción de una oficina temporal del Servicio Postal de EE.UU. Aunque estaba previsto que el edificio fuera demolido la próxima primavera y reconectado con el área de Nicollet Mall, un incendio que se produjo en el edificio vacío el mes pasado aceleró ese proceso. Como informó anteriormente Canal 5 ABC, los trabajos de preparación para la demolición comenzaron la semana pasada.
El incendio del 20 de octubre provocó el colapso del lado norte del edificio. No había nadie dentro del edificio en el momento del incendio, dicen los equipos. El Ayuntamiento de Minneapolis ya aprobó un contrato de 640.000 dólares con una empresa constructora para impulsar la demolición, aunque el lote permanecerá vacío una vez despejado, ya que la construcción no comenzará hasta 2025.